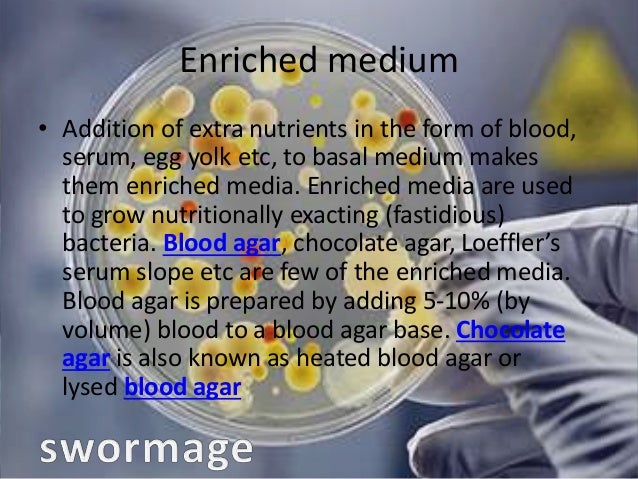

Why is agar used for growing bacteria
Why Is Agar Used For Growing Bacteria. From the depths of the oceans to the mouths of the hot water vents in the seabed the driest deserts the snow capped peaks the muddiest puddle you jumped in during your childho. Agar is a gelatinous medium that provides nutrients and a stable controlled environment for bacteria growth agar solution. Nutrient agar is popular because it can grow a variety of types of bacteria and fungi and contains many nutrients needed for the bacterial growth. The reason agar is used to grow bacteria is because of its gel like properties.
 Nutrient Agar Composition Preparation And Uses From microbiologyinfo.com
Nutrient Agar Composition Preparation And Uses From microbiologyinfo.com
Agar is a type of sugar in a gelatinous form made from algae and typically used to grow bacteria in a lab. It is in fact one of the most distinctive of those materials mostly because of its unique smell. Two indicator dyes eosin and methylene blue inhibit the growth of gram positive bacteria and distinguish between lactose fermenting and nonlactose fermenting organisms. From the depths of the oceans to the mouths of the hot water vents in the seabed the driest deserts the snow capped peaks the muddiest puddle you jumped in during your childho. Agar is a gelatinous medium that provides nutrients and a stable controlled environment for bacteria growth agar solution. Bacteria eat the agar and help scientists perform culture tests.
The reason agar is used to grow bacteria is because of its gel like properties.
Nutrient agar is popular because it can grow a variety of types of bacteria and fungi and contains many nutrients needed for the bacterial growth. Nutrient agar is popular because it can grow a variety of types of bacteria and fungi and contains many nutrients needed for the bacterial growth. They do not need agar to grow in or on. The reason agar is used to grow bacteria is because of its gel like properties. Nutrient agar is usually used for growth of nonfastidious organisms and observation of pigment production. It is important that very few organisms degrade agar that s why it is the carbohydrate of choice as a base for culture media.
Source: slideshare.net
Source: slideshare.net
Two indicator dyes eosin and methylene blue inhibit the growth of gram positive bacteria and distinguish between lactose fermenting and nonlactose fermenting organisms. Two indicator dyes eosin and methylene blue inhibit the growth of gram positive bacteria and distinguish between lactose fermenting and nonlactose fermenting organisms. Nutrient agar is a general purpose nutrient medium used for the cultivation of microbes supporting growth of a wide range of non fastidious organisms. Emb agar is a medium used in the identification and isolation of pathogenic bacteria. More over it supports the colonies so we can see and test them.
 Source: stevespanglerscience.com
Source: stevespanglerscience.com
Bacteria eat the agar and help scientists perform culture tests. Two indicator dyes eosin and methylene blue inhibit the growth of gram positive bacteria and distinguish between lactose fermenting and nonlactose fermenting organisms. Emb agar is a medium used in the identification and isolation of pathogenic bacteria. It allows nutrients to be evenly suspended within it while being non toxic to literally every organism cultured to date. It is safe to use in school science laboratories because it does not selectively grow pathogenic bacteria.
 Source: madaboutscience.com.au
Source: madaboutscience.com.au
They do not need agar to grow in or on. The reason agar is used to grow bacteria is because of its gel like properties. Because it make a semi solid material for the bacterial cells to move easily but at the same time it cannot be consumed by this bacterial as a source of food. The reason agar is used to grow bacteria is because of its gel like properties. Composition of nutrient agar 0 5 peptone.
 Source: wikihow.com
Source: wikihow.com
They do not need agar to grow in or on. Bacteria can grow anywhere. It allows nutrients to be evenly suspended within it while being non toxic to literally every organism cultured to date. Because it make a semi solid material for the bacterial cells to move easily but at the same time it cannot be consumed by this bacterial as a source of food. Nutrient agar is a general purpose nutrient medium used for the cultivation of microbes supporting growth of a wide range of non fastidious organisms.
 Source: en.wikipedia.org
Source: en.wikipedia.org
Nutrient agar is a general purpose nutrient medium used for the cultivation of microbes supporting growth of a wide range of non fastidious organisms. Emb agar is a medium used in the identification and isolation of pathogenic bacteria. They do not need agar to grow in or on. It contains digested meat proteins as a source of organic nutrients. Nutrient agar is popular because it can grow a variety of types of bacteria and fungi and contains many nutrients needed for the bacterial growth.
 Source: slideplayer.com
Source: slideplayer.com
It is in fact one of the most distinctive of those materials mostly because of its unique smell. Agar is a gelatinous medium that provides nutrients and a stable controlled environment for bacteria growth agar solution. The reason agar is used to grow bacteria is because of its gel like properties. It is in fact one of the most distinctive of those materials mostly because of its unique smell. From the depths of the oceans to the mouths of the hot water vents in the seabed the driest deserts the snow capped peaks the muddiest puddle you jumped in during your childho.
 Source: giftofcuriosity.com
Source: giftofcuriosity.com
Bacteria can grow anywhere. The reason agar is used to grow bacteria is because of its gel like properties. The reason agar is used to grow bacteria is because of its gel like properties. They do not need agar to grow in or on. Bacteria eat the agar and help scientists perform culture tests.
 Source: stevespanglerscience.com
Source: stevespanglerscience.com
Emb agar is a medium used in the identification and isolation of pathogenic bacteria. Composition of nutrient agar 0 5 peptone. More over it supports the colonies so we can see and test them. Agar is a type of sugar in a gelatinous form made from algae and typically used to grow bacteria in a lab. Agar is a gelatinous medium that provides nutrients and a stable controlled environment for bacteria growth agar solution.
 Source: docbrown.info
Source: docbrown.info
More over it supports the colonies so we can see and test them. Agar is one of those materials that can be found in science laboratories. It is perfect for growing non selective heterotrophic bacteria. The reason agar is used to grow bacteria is because of its gel like properties. Two indicator dyes eosin and methylene blue inhibit the growth of gram positive bacteria and distinguish between lactose fermenting and nonlactose fermenting organisms.
 Source: madaboutscience.com.au
Source: madaboutscience.com.au
Agar is a type of sugar in a gelatinous form made from algae and typically used to grow bacteria in a lab. The reason agar is used to grow bacteria is because of its gel like properties. Emb agar is a medium used in the identification and isolation of pathogenic bacteria. Agar is a type of sugar in a gelatinous form made from algae and typically used to grow bacteria in a lab. More over it supports the colonies so we can see and test them.
 Source: docbrown.info
Source: docbrown.info
The reason agar is used to grow bacteria is because of its gel like properties. It is perfect for growing non selective heterotrophic bacteria. Two indicator dyes eosin and methylene blue inhibit the growth of gram positive bacteria and distinguish between lactose fermenting and nonlactose fermenting organisms. Emb agar is a medium used in the identification and isolation of pathogenic bacteria. Agar is one of those materials that can be found in science laboratories.
 Source: smithsonianmag.com
Source: smithsonianmag.com
They do not need agar to grow in or on. They do not need agar to grow in or on. Nutrient agar is a general purpose nutrient medium used for the cultivation of microbes supporting growth of a wide range of non fastidious organisms. Agar is a type of sugar in a gelatinous form made from algae and typically used to grow bacteria in a lab. It allows nutrients to be evenly suspended within it while being non toxic to literally every organism cultured to.
 Source: en.wikipedia.org
Source: en.wikipedia.org
They do not need agar to grow in or on. Agar is a gelatinous medium that provides nutrients and a stable controlled environment for bacteria growth agar solution. It allows nutrients to be evenly suspended within it while being non toxic to literally every organism cultured to date. It is safe to use in school science laboratories because it does not selectively grow pathogenic bacteria. The reason agar is used to grow bacteria is because of its gel like properties.
 Source: microbiologyinfo.com
Source: microbiologyinfo.com
It allows nutrients to be evenly suspended within it while being non toxic to literally every organism cultured to date. It allows nutrients to be evenly suspended within it while being non toxic to literally every organism cultured to. Agar is one of those materials that can be found in science laboratories. Nutrient agar is a general purpose nutrient medium used for the cultivation of microbes supporting growth of a wide range of non fastidious organisms. Because it make a semi solid material for the bacterial cells to move easily but at the same time it cannot be consumed by this bacterial as a source of food.
 Source: scienceprofonline.com
Source: scienceprofonline.com
Nutrient agar is a general purpose nutrient medium used for the cultivation of microbes supporting growth of a wide range of non fastidious organisms. It allows nutrients to be evenly suspended within it while being non toxic to literally every organism cultured to date. It is perfect for growing non selective heterotrophic bacteria. Nutrient agar is a general purpose nutrient medium used for the cultivation of microbes supporting growth of a wide range of non fastidious organisms. Bacteria can grow anywhere.
If you find this site helpful, please support us by sharing this posts to your favorite social media accounts like Facebook, Instagram and so on or you can also save this blog page with the title why is agar used for growing bacteria by using Ctrl + D for devices a laptop with a Windows operating system or Command + D for laptops with an Apple operating system. If you use a smartphone, you can also use the drawer menu of the browser you are using. Whether it’s a Windows, Mac, iOS or Android operating system, you will still be able to bookmark this website.






